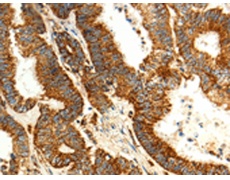
一抗

中文名稱: 兔抗MAP1LC3A多克隆抗體
英文名稱: Anti-MAP1LC3A rabbit polyclonal antibody
別 名: LC3; LC3A; ATG8E; MAP1ALC3; MAP1BLC3
抗 原: MAP1LC3A
儲 存: 冷凍(-20℃)
宿 主: Rabbit
相關(guān)類別: 一抗
反應(yīng)種屬: Human, Mouse, Rat
標(biāo) 記 物: Unconjugate
克隆類型: rabbit polyclonal
技術(shù)規(guī)格
Background:
MAP1A and MAP1B are microtubule-associated proteins which mediate the physical interactions between microtubules and components of the cytoskeleton. MAP1A and MAP1B each consist of a heavy chain subunit and multiple light chain subunits. The protein encoded by this gene is one of the light chain subunits and can associate with either MAP1A or MAP1B. Two transcript variants encoding different isoforms have been found for this gene. The expression of variant 1 is suppressed in many tumor cell lines, suggesting that may be involved in carcinogenesis.
Applications:
ELISA, IHC
Name of antibody:
MAP1LC3A
Immunogen:
Fusion protein of human MAP1LC3A
Full name:
microtubule-associated protein 1 light chain 3 alpha
Synonyms:
LC3; LC3A; ATG8E; MAP1ALC3; MAP1BLC3
SwissProt:
Q9H492
ELISA Recommended dilution:
2000-5000
IHC positive control:
Human colon cancer and human gastric cancer
IHC Recommend dilution:
25-100

 購物車
購物車 幫助
幫助
 021-54845833/15800441009
021-54845833/15800441009